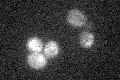
YDR287W

View description
Inositol monophosphatase, involved in biosynthesis of inositol; enzymatic activity requires magnesium ions and is inhibited by lithium and sodium ions; inm1 inm2 double mutant lacks inositol auxotrophy
Localization:
Intensity:
Fold change:
Significance:
-
C’ GFP library in SD

below threshold17.57 -
N' NOP1pr-GFP in SD

cytosol88.2843 -
N' TEF2pr-mCherry in SD

missing0 -
N' NATIVEpr-GFP in SD

below threshold18.5289 -
N' TEF2pr-VC and Cyto-VN in SD

#N/A0 -
C’ GFP library in SD+DTT

cytosol17.921.02No -
C’ GFP library in SD+H2O2
cytosol16.70.95No -
C’ GFP library in Starvation Media

cytosol15.720.89No -
C’ GFP library on the background of Pup2-DaMP

below threshold -
C’ GFP library on the background of CCT mutant

below threshold20.30481.15555No
